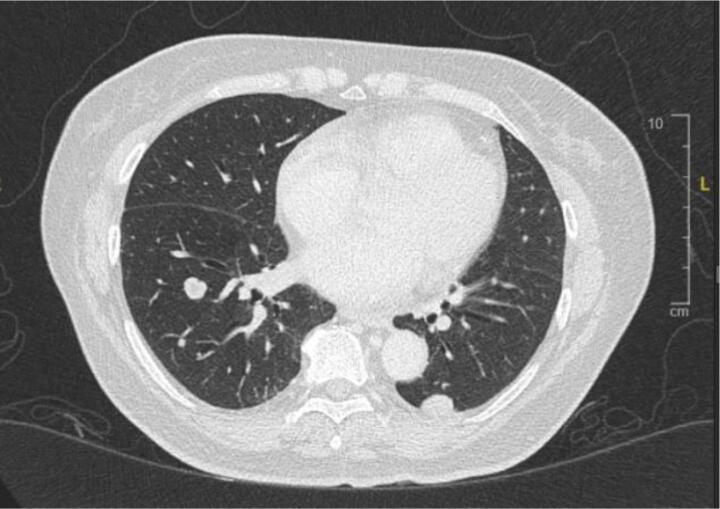
Fig. 2C

Highlights
-
•
68-year-old female patient with stage IVB, recurrent, progressive uterine leiomyosarcoma with lung metastases.
-
•
Immunohistochemistry PD-L1 positive, not mismatch repair deficient.
-
•
Previously treated with gemcitabine + docetaxel, pazopanib, eribulin, and doxorubicin + cyclophosphamide.
-
•
Fifth-line treatment with pembrolizumab and temozolomide combination demonstrates durable, partial response at cycle 7.
-
•
Ongoing treatment at time of submission is well tolerated with minimal toxicity.
Keywords: Refractory uterine leiomyosarcoma, Combination therapy, Pembrolizumab, Temzolomide, Uterine malignancy, Immunotherapy
Abstract
Uterine leiomyosarcomas (ULMS) are a rare cause of uterine malignancy. Due to their aggressive nature, resistance to standard therapy and high rates of recurrence, they are associated with a very poor prognosis, irrespective of their stage at diagnosis. A 68-year-old female, Chinese patient was diagnosed with Stage IVB uterine leiomyosarcoma with lung metastasis. Disease progression occurred after fourth-line treatment and the patient was commenced on pembrolizumab and temozolomide combination therapy. At the time of writing, our patient has experienced partial response to treatment with minimal adverse effects at cycle 7 of Pembrolizumab in combination with Temozolomide.
1. Background
Uterine leiomyosarcomas (ULMS) are a rare cause of uterine malignancy, arising from the smooth muscle cells in the myometrium. Due to their aggressive nature, resistance to standard therapy and high rates of recurrence, they are associated with a very poor prognosis, despite their stage. Stage IV disease has a 5-year disease-specific-survival rate of only 28.7 % (Kapp et al., 2008).
Management of early-stage disease comprises of surgical resection by way of a total hysterectomy with or without salpingo-oophorectomy and lymph node dissection. Adjuvant therapy for International Federation of Gynecology and Obstetrics (FIGO) stage I-II disease has failed to show any long-term reduction in risk of relapse or improvements in clinical outcome. (Rizzo et al., 2019) Early stage ULMS has been shown to have recurrence rates between 50 and 60 %. (Ricci et al., 2013).
For more advanced disease, primary surgery is still indicated, in those that are fit enough to tolerate the procedure. As opposed to early-stage disease, adjuvant therapy for advanced, metastatic disease has been shown to increase overall survival. (Seagle et al., 2017) As per the National Comprehensive Cancer Network (NCCN) guidelines, treatment options for advanced, recurrent, or metastatic ULMS include single-agent or combination cytotoxic therapy. Single-agent considerations include “dacarbazine, doxorubicin, epirubicin, gemcitabine, ifosfamide, liposomal doxorubicin, pazopanib, temozolomide, vinorelbine, and docetaxel”. Combination therapy includes “gemcitabine/docetaxel, doxorubicin/ifosfamide, doxorubicin/dacarbazine, doxorubicin/trabectedin, gemcitabine/dacarbazine, and gemcitabine/vinorelbine”. If the cancer does not respond/stops responding to first-line treatment, other regimens as listed above are tried. However, there is currently no universally accepted sequence of multiagent chemotherapies. (Koh et al., 2015).
Alternative therapies such as immunotherapy have been proposed, but there is still currently a paucity in literature surrounding subsequent lines of treatment for metastatic or recurrent ULMS. Although the role of immunotherapy in this setting remains largely unclear at present, a case report by Wang et al. in 2021 describes a case of ULMS that demonstrated a prolonged response to treatment with a PDL-1 inhibitor, Pembrolizumab. (Wang et al., 2021).
Temozolomide is a chemotherapeutic agent that is not currently a mainstay of treatment for ULMS, but has been shown to provide a good response in some select patients with ULMS that have failed first-line treatment. (Ridolfi et al., 2013) Additionally, temozolomide combined with a checkpoint inhibitor, olaparib, has been shown to effectively inhibit tumour growth in ULMS. This indicates temozolomide may act as a good chemotherapeutic backbone for additional checkpoint inhibitors. (Ingham et al., 2023).
These studies provided the impetus behind the regimen of pembrolizumab and temozolomide described in this case report. Novel therapeutic agents for recurrent, metastatic, or unresponsive ULMS is currently an area of high unmet clinical need. This case report highlights a treatment avenue that could be used by others looking for late-line therapeutic options.
2. Case
A 68-year-old Chinese woman was diagnosed with Stage IVB ULMS (spindle type) with lung metastasis in January 2021. Initial computed tomography (CT) revealed a uterine mass measuring 7.5 x 6.3x 5 cm (Fig. 2A), and multiple lung metastases (Fig. 2B). She underwent total abdominal hysterectomy with bilateral salpingo-oophorectomy (TAHBSO) and omentectomy in January 2021. Histopathological report revealed the tumour to be a malignant uterine tumour involving the myometrium, consisting of predominantly malignant spindle cells. Immunohistochemistry (IHC) report confirmed a profile consistent with ULMS. Estrogen Receptor/Progesterone Receptor negative. The patient was started on first line palliative chemotherapy: Gemcitabine and Docetaxel. She completed 6 cycles of this regimen in July 2021. CT reassessment at this point showed stable lung lesions (Fig. 2C). Following a one-month treatment break, CT imaging revealed an increase in size of the lung lesions, with no new lesions. The patient was then started on Pazopanib 800 mg OD. This was stopped after 3 months, due to treatment toxicity - Hand-Foot-Syndrome (HFS), associated with transaminitis and proteinuria. The patient was then started on Eribulin as third line treatment. She remained on this for 4 months until June 2022. CT imaging revealed disease progression, with new enhancing lesions suggestive of right-sided abdominopelvic recurrence and worsening lung and pleural base metastases (largest measuring 3.3x5.2x7.7 cm, previously 1.9x2.5x2.7 cm). The patient’s regimen was then changed to Doxorubicin and Cyclophosphamide. Although there is no universally accepted sequence of palliative chemotherapeutic agents, doxorubicin with cyclophosphamide is often attempted as first or second-line treatment. This was avoided in an early-line setting in this case to minimise the risk of cardiac toxicity. After 4 cycles of this regimen in September 2022, CT revealed further disease progression with increasing abdominopelvic enhancing recurrence, worsening lung and pleural-based metastases and liver metastases (Fig. 2D).
Fig. 2A.
Uterine mass.
Fig. 2B.
Initial lung lesions pre-chemotherapy.
Fig. 2C.
Lung lesions post Gemcitabine.
Fig. 2D.
Post Doxorubicin + Cyclophosphamide + Docetaxel.
Further IHC staining of the tumour revealed PD-L1 positivity, with a combined positive score (CPS) of 15. Screening for microsatellite instability revealed no loss of expression of MLH1, MSH2, and PMS2 proteins, demonstrating no evidence of MMR deficient. No further IHC studies were conducted.
In view of PD-L1 status of the tumour, she was started on immune checkpoint blockade. The decision was made to start on combination of pembrolizumab 200 mg, 4 weekly and temozolomide 300 mg D1-5, 4 weekly. CT after completion of cycle 4 revealed a reduction in right abdominopelvic mass size (3.4x2.2x2.4 cm, previously 7.2x5.2x5.6 cm), lung and pleural-based metastases (1.3x3.6x3.1 cm, previously 3.3x6.0x7.7 cm)(Fig. 2E). She was continued on the current regimen and is now on cycle 7. Patient has tolerated this regimen well throughout all cycles with minimal toxicity (Fig. 1).
Fig. 2E.
Response post Pembrolizumab + Temozolomide.
Fig. 1.
Timeline of Treatment.
3. Discussion
Leiomyosarcomas (LMS) are rare, aggressive cancers that originate from smooth muscle. The most common site of LMS is the smooth muscle cells of the uterine myometrium, with uterine LMS making up between 2 and 5 % of all uterine malignancies (Rizzo et al., 2019). Uterine leiomyosarcomas often present with nausea and vomiting, non-discriminant abdominal pain, abnormal vaginal bleeding, and abdominal fullness. It is an aggressive cancer, one that often rapidly develops a resistance to initial lines of treatment, and one that has a high rate of recurrence. Despite 60 % of patients being diagnosed with early-stage disease, prognosis remains poor (D’Angelo and Prat, 2010). The 5-year disease specific survival (DSS) rate for patients with FIGO stage I disease was 75.8 % and stage II was 60.1 %. For stage III and IV disease, DSS rates were 44.9 % and 28.7 %, respectively, with a greater propensity to recur and metastasise (Kapp et al., 2008). This is the first case report describing the response to combination of pembrolizumab and temozolomide for systemic treatment of ULMS refractory to multiple lines of chemotherapy.
The treatment of localised uterine LMS is complete surgical resection with an abdominal hysterectomy. The addition of bilateral salpingo-ophorectomy remains controversial, with no impact on overall survival (Kapp et al., 2008). Adjuvant radiotherapy has shown no improvement in overall survival (OS) or progression free survival (PFS) in LMS (Reed et al., 2008). Therefore, once disease progression occurs, remaining treatment modality options include chemotherapy and targeted therapy, such as monoclonal antibodies. The most ideal therapeutic regimen is still yet to be determined.
In terms of adjuvant chemotherapy, the National Comprehensive Cancer Network (NCCN) guidelines state treatment options for advanced, recurrent, or metastatic ULMS include single-agent or combination cytotoxic therapy. Single-agent considerations include “dacarbazine, doxorubicin, epirubicin, gemcitabine, ifosfamide, liposomal doxorubicin, pazopanib, temozolomide, vinorelbine, and docetaxel”. Combination therapy includes “gemcitabine/docetaxel, doxorubicin/ifosfamide, doxorubicin/dacarbazine, doxorubicin/trabectedin, gemcitabine/dacarbazine, and gemcitabine/vinorelbine”. If the cancer does not respond/stops responding to first-line treatment, other regimens as listed above are tried. However, there is currently no universally accepted sequence of multiagent chemotherapies. (Koh et al., 2015).
Scientific advancement in molecular testing has led to greater research in targeted cancer therapies. Immunotherapy has been one of the latest advancements in the field of oncology, and has gained increasing attention in the treatment of solid tumours. Pembrolizumab is a PD-1 blocking antibody that allows the immune system to mount an appropriate response against tumour cells.
The role of immunotherapy in the treatment of ULMS however, remains unclear. There have been some cases reported on usage of PD-1 inhibitors, however the outcome of these cases is varied, and no clear conclusions can be made on the efficacy of PD-1 inhibitor in metastatic ULMS. (Ben-Ami et al., 2017, Miao et al., 2016) Wang et al. described a case of MSI-H ULMS, responding to Pembrolizumab in her case report. (Wang et al., 2021) There are no extensive studies made on the role of PDL-1 expression, as well as MSI/MMR status on the efficacy of immunotherapy for ULMS. The extent of PDL-1 expression, as well as MSI/MMR status may be clinically predictive and can guide treatment for a subset of patients who may benefit from immune checkpoint blockades. With regards to our case, her tumour profiling revealed a PDL-1 CPS score of 15, which may be a predictive factor for her response to immunotherapy as described.
Temozolomide is a chemotherapeutic agent that has previously been successful in the treatment of brain tumours, primarily gliomas. It works as a methylating agent, preventing DNA replication and thus cell replication. Temozolomide has previously demonstrated promising therapeutic benefit as a stand-alone therapy in the treatment of recurrent or metastatic uterine leiomyosarcoma previously treated with doxorubicin-based chemotherapy. Patients were placed on a continuous daily-dose regimen or a bolus-dose regimen and achieved response rates of 8 % and 14 %, respectively. Stable disease was also achieved in 33 % of those on continuous-daily dose regimen for 2–5 or more cycles and 57 % in those undergoing daily-bolus treatment achieved stable disease for 3–16 cycles (Anderson and Aghajanian, 2005). Temozolomide has been shown to have a synergistic effect when combined with other therapeutic agents. Temozolomide in combination with the monoclonal antibody bevacizumab (an antiangiogenic agent targeting VEGF) for patients with heavily pre-treated ULMS demonstrated 18 % demonstrated complete response, 12 % partial response and 41 % stable disease. The median progression-free-survival was 14.2 months (Matsuura et al., 2017). The phase-2 “MAYA” trial has shown promise in the treatment of microsatellite-stable (MSS), metastatic colorectal cancer with temozolomide. The chemotherapeutic agent acted as a priming agent, creating neoantigens and sensitising the immune system, leaving the tumour more susceptible to subsequent treatment with combination ipilimumab and nivolumab – both immunotherapeutic agents. Median PFS was 7.0 months and overall survival was 18.4 months in this study, with 45 % overall response rate. This study provided proof-of-concept evidence that this sequence can result in durable clinical benefit. (Morano et al., 2022).
Additionally, there are ongoing clinical trials investigating response of Temozolomide and Olaparib in metastatic ULMS, which could provide an alternative treatment regimen for this subset of patients (ClinicalTrials.gov Identifier NCT05633381).
These studies provided impetus to trial the combination of temozolomide and pembrolizumab discussed in this case.
One limitation of this study is that we did not obtain further IHC staining or a full molecular profile in this case. This would have been beneficial to identify additional markers that could have affected the outcomes of this report.
4. Conclusion
This is the first case report to demonstrate that combination therapy with pembrolizumab and temozolomide provides durable clinical benefit in the treatment of recurrent, metastatic ULMS that has progressed on conventional therapy.
Although still in its early stages, the reduction in tumour size as demonstrated on CT alongside reduced toxicity burden are very promising. This case report highlights the novel combination of pembrolizumab and temozolomide and its potential for further research and clinical management for a disease that currently has a poor overall prognosis with very limited treatment options.
CRediT authorship contribution statement
Rebecca Lin: Writing – original draft, Writing – review & editing. Asyraf Muaadz: Data curation, Writing – review & editing. Ho Gwo Fuang: Conceptualization, Supervision, Writing – review & editing.
Declaration of competing interest
The authors declare that they have no known competing financial interests or personal relationships that could have appeared to influence the work reported in this paper.
References
- Anderson S., Aghajanian C. Temozolomide in uterine leiomyosarcomas. Gynecol. Oncol. 2005 Jul;98(1):99–103. doi: 10.1016/j.ygyno.2005.03.018. [DOI] [PubMed] [Google Scholar]
- Ben-Ami E., Barysauskas C.M., Solomon S., Tahlil K., Malley R., Hohos M., et al. Immunotherapy with single agent nivolumab for advanced leiomyosarcoma of the uterus: Results of a phase 2 study. Cancer. 2017 Sep 1;123(17):3285–3290. doi: 10.1002/cncr.30738. [DOI] [PMC free article] [PubMed] [Google Scholar]
- D’Angelo E., Prat J. Uterine sarcomas: A review. Gynecol. Oncol. 2010 Jan;116(1):131–139. doi: 10.1016/j.ygyno.2009.09.023. [DOI] [PubMed] [Google Scholar]
- Ingham M., Allred J.B., Chen L., Das B., Kochupurakkal B., Gano K., et al. Phase II study of Olaparib and temozolomide for advanced uterine leiomyosarcoma (NCI protocol 10250) J. Clin. Oncol. 2023;41(25):4154–4163. doi: 10.1200/jco.23.00402. [DOI] [PMC free article] [PubMed] [Google Scholar]
- Kapp D.S., Shin J.Y., Chan J.K. Prognostic factors and survival in 1396 patients with uterine leiomyosarcomas. Cancer. 2008 Feb 15;112(4):820–830. doi: 10.1002/cncr.23245. [DOI] [PubMed] [Google Scholar]
- Koh W.-J., Greer B.E., Abu-Rustum N.R., Apte S.M., Campos S.M., Cho K.R., et al. Uterine sarcoma, version 1.2016. J. Natl. Compr. Canc. Netw. 2015;13(11):1321–1331. doi: 10.6004/jnccn.2015.0162. [DOI] [PubMed] [Google Scholar]
- Matsuura H., Ikeda S., Kudoh K., Sasaki N., Takano M., Goto T., et al. Effects of temozolomide and bevacizumab in relapsed patients with heavily pretreated uterine leiomyosarcoma. J. Clin. Oncol. 2017 May 20;35(15_suppl):11056. [Google Scholar]
- Miao D., Adeegbe D., Rodig S.J., Shukla S., Amin-Mansour A., Carter S.L., et al. Response and oligoclonal resistance to pembrolizumab in uterine leiomyosarcoma: Genomic, neoantigen, and immunohistochemical evaluation. J. Clin. Oncol. 2016 May 20;34(15_suppl):11043. [Google Scholar]
- Morano F., Raimondi A., Pagani F., Lonardi S., Salvatore L., Cremolini C., et al. Temozolomide followed by combination with low-dose ipilimumab and nivolumab in patients with microsatellite-stable, O6-methylguanine–DNA methyltransferase–silenced metastatic colorectal cancer: The maya trial. J. Clin. Oncol. 2022;40(14):1562–1573. doi: 10.1200/jco.21.02583. [DOI] [PMC free article] [PubMed] [Google Scholar]
- Reed N.S., Mangioni C., Malmström H., Scarfone G., Poveda A., Pecorelli S., et al. Phase III randomised study to evaluate the role of adjuvant pelvic radiotherapy in the treatment of uterine sarcomas stages I and II: An European Organisation for Research and Treatment of Cancer Gynaecological Cancer Group Study (protocol 55874) Eur. J. Cancer. 2008 Apr;44(6):808–818. doi: 10.1016/j.ejca.2008.01.019. [DOI] [PubMed] [Google Scholar]
- Ricci S., Giuntoli R.L., Eisenhauer E., Lopez M.A., Krill L., Tanner E.J., et al. Does adjuvant chemotherapy improve survival for women with early-stage uterine leiomyosarcoma? Gynecol. Oncol. 2013;131(3):629–633. doi: 10.1016/j.ygyno.2013.08.037. [DOI] [PubMed] [Google Scholar]
- Ridolfi C., Pasini G., Drudi F., Barzotti E., Santelmo C., Polselli A., et al. Long lasting clinical response to chemotherapy for advanced uterine leiomyosarcoma: A case report. J. Med. Case Rep. 2013;7(1) doi: 10.1186/1752-1947-7-29. [DOI] [PMC free article] [PubMed] [Google Scholar]
- Rizzo A., Pantaleo M.A., Saponara M., Nannini M. Current status of the adjuvant therapy in uterine sarcoma: A literature review. World J. Clin. Cases. 2019;7(14):1753–1763. doi: 10.12998/wjcc.v7.i14.1753. [DOI] [PMC free article] [PubMed] [Google Scholar]
- Seagle B.-L.-L., Sobecki-Rausch J., Strohl A.E., Shilpi A., Grace A., Shahabi S. Prognosis and treatment of uterine leiomyosarcoma: A national cancer database study. Gynecol. Oncol. 2017;145(1):61–70. doi: 10.1016/j.ygyno.2017.02.012. [DOI] [PubMed] [Google Scholar]
- Wang Y.J., Williams H.R., Brzezinska B.N., Gaidis A., Patel B., Munroe J., et al. Use of pembrolizumab in MSI-high uterine leiomyosarcoma; a case report and review of the literature. Gynecol. Oncol. Rep. 2021 Feb;35 doi: 10.1016/j.gore.2021.100701. [DOI] [PMC free article] [PubMed] [Google Scholar]